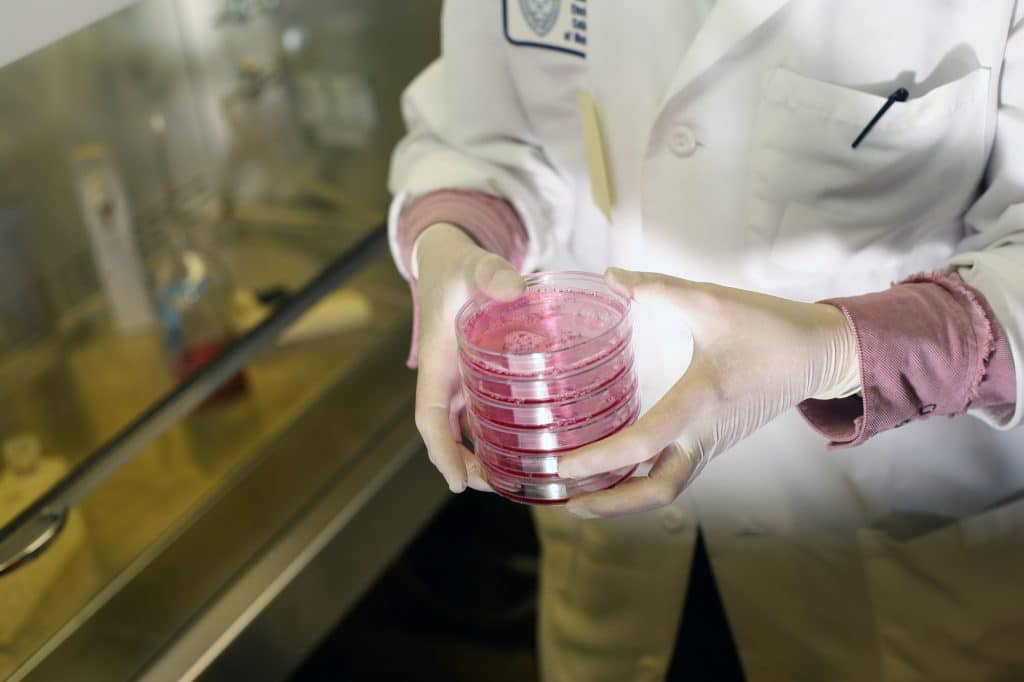

Discovery platform
R&D and pilot fermentation resources
Our state-of-the-art R&D facility, located in the Lille Metropole area, has all the equipment needed to carry out research programs on microbial strain screening and characterization.
- Fully equipped discovery platform (microbiology, biochemistry, cell culture laboratories) for characterization of microbial strains, screening of biological activities, biomolecule identification.
- Pilot production line for specialty fermentation and starter strain production (2L to 30L bioreactors, concentration, freeze-drying…).

Microbiology expertise
Our R&D programs focus on lactic acid bacteria characterization, and on the exploration of their potential for industrial applications.
- Probiotic strain characterization : antibiotic resistance, safety, GIT survival…
- Fermentation process development : optimization of bacterial growth and metabolic activity in batch- or continuous systems, development of fermentation media (dairy, non-dairy…).


Bioactivity screening
We can evaluate the probiotic properties of microbial strains using in vitro, in vivo, and human clinical studies.
- Cell culture models (adherent on non-adherent, multi-layer cultures, organoids). Available models include intestinal cells (Caco-2, HT-29 : gut health, permeability), liver cells (HepG2 : liver protection), keratinocytes (HaCat : inflammation, apoptosis for skin health), macrophages (U937 : immune function).
- Bioanalyses : flow cytometry, qPCR for gene expression, spectrometry and spectrofluorometry for biochemical testing (ELISA, enzymatic activities, cell function and cell cycle assays…).

Bioinformatics
We are using proprietary, AI-based bioinformatics tools to analyse microbial whole genome sequences and predict the strain safety (antibiotic resistance, virulence factors), technological characteristics and potential probiotic properties.


Collaborative research
VF Bioscience has the French CIR accreditation to work as a CRO and offers contract or collaborative research services.